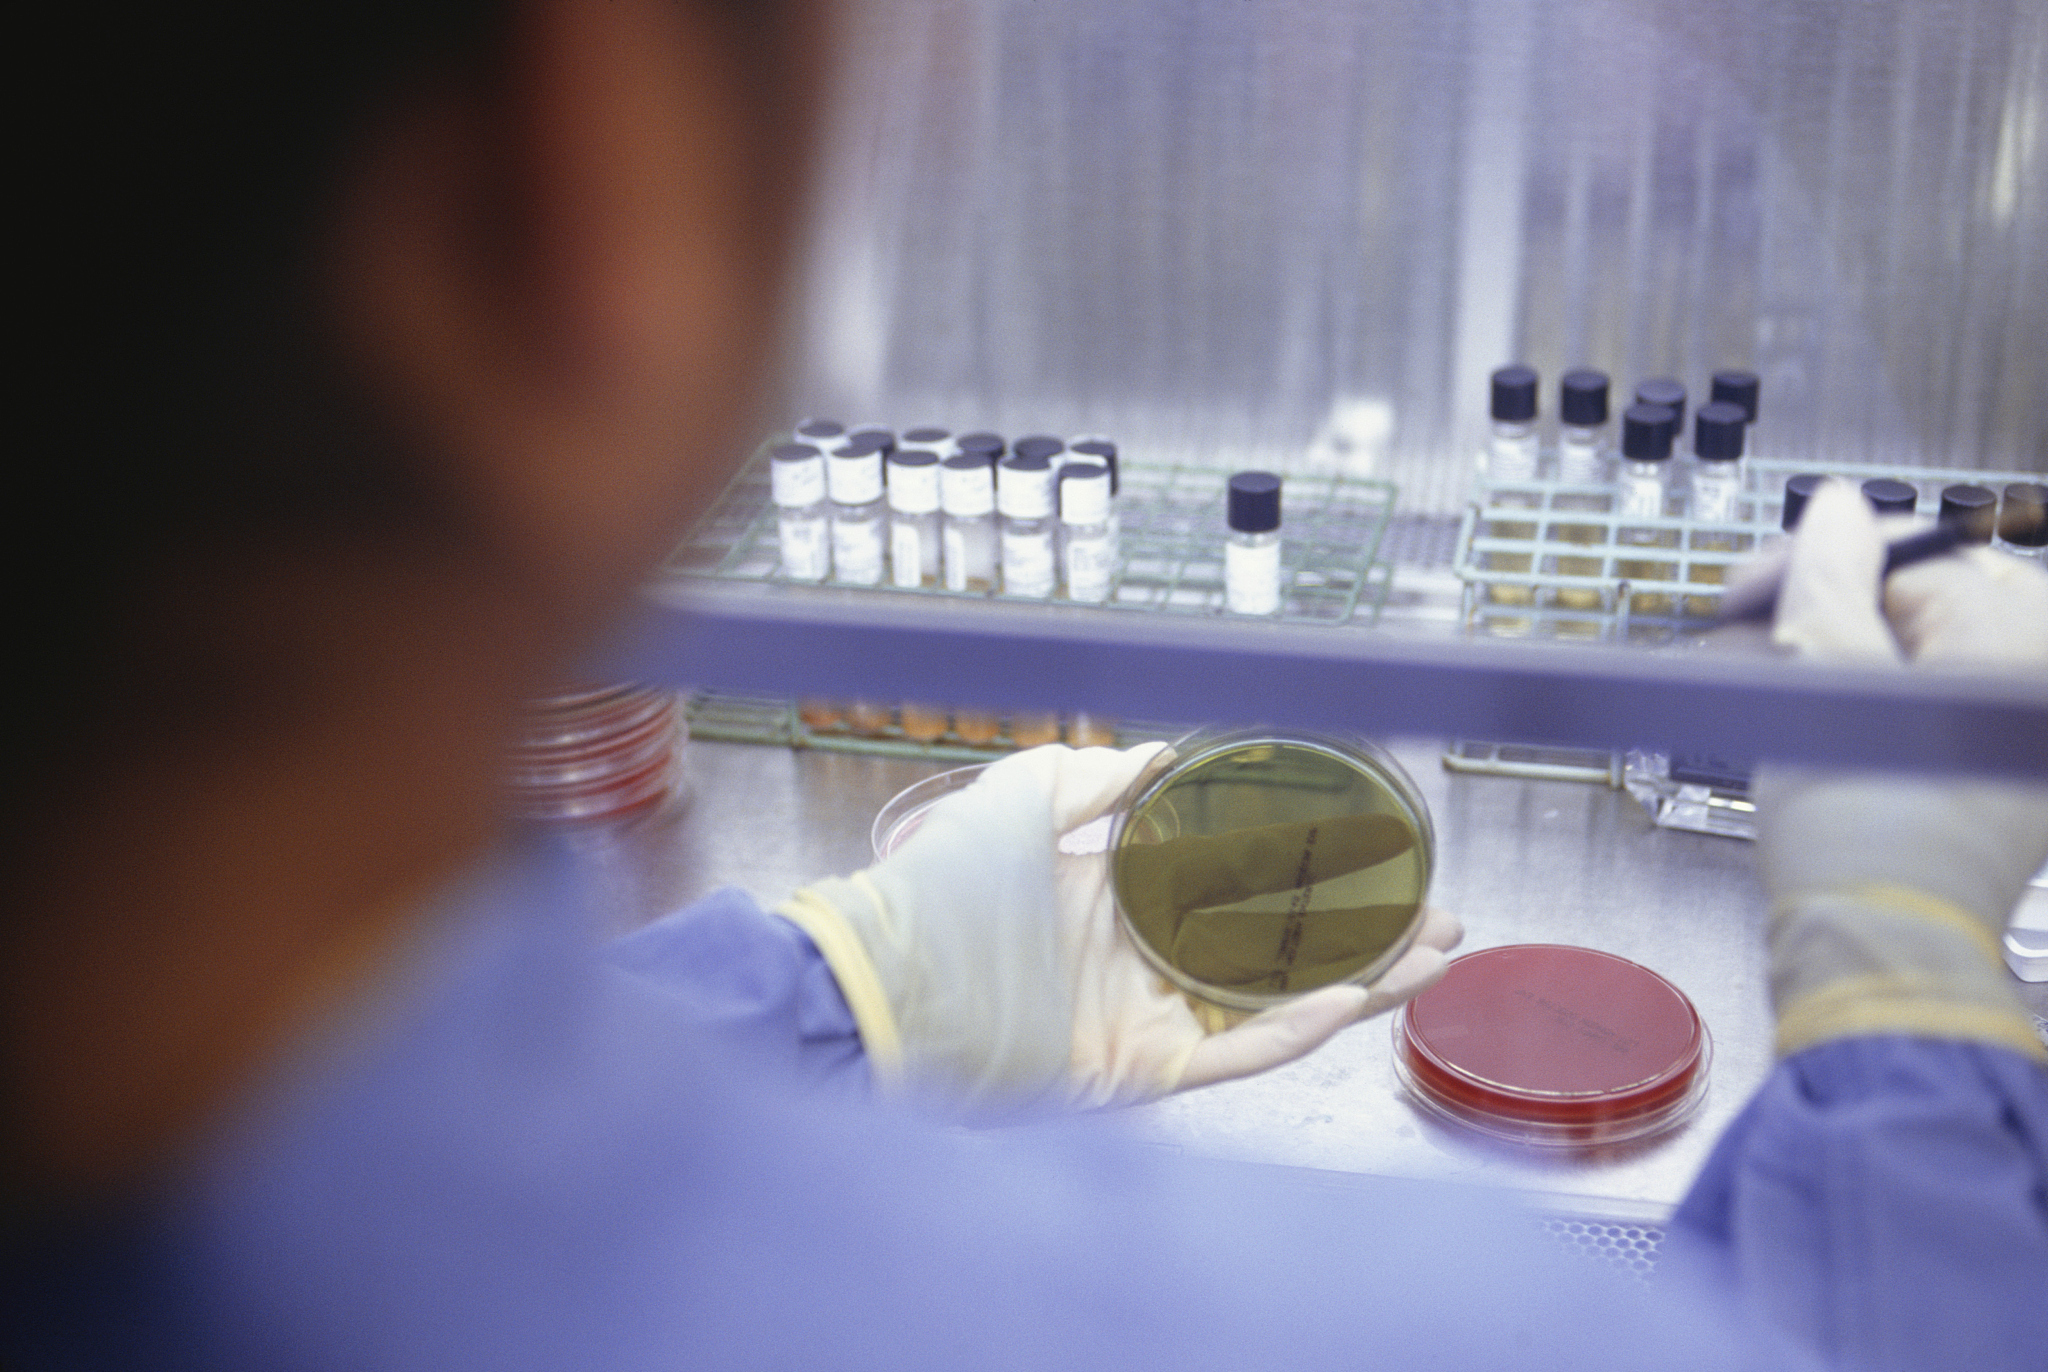
渐冻症可以治疗吗？

渐冻症可以治疗吗?
目前尚无针对渐冻症的治愈方法,但可以通过药物治疗、康复训练和支持性治疗来缓解症状,延缓病情进展。药物治疗主要是使用多巴胺受体激动剂和谷氨酸拮抗剂等药物来改善肌肉僵硬和震颤等症状。康复训练可以帮助患者保持肌肉力量和协调能力,缓解肌肉僵硬和震颤等症状。支持性治疗包括营养支持、呼吸支持和心理支持等,可以提高患者的生活质量。

原文地址: https://www.cveoy.top/t/topic/bDv2 著作权归作者所有。请勿转载和采集!
安全问答是一个知识全球问答,包含丰富的问答知识
目前尚无针对渐冻症的治愈方法,但可以通过药物治疗、康复训练和支持性治疗来缓解症状,延缓病情进展。药物治疗主要是使用多巴胺受体激动剂和谷氨酸拮抗剂等药物来改善肌肉僵硬和震颤等症状。康复训练可以帮助患者保持肌肉力量和协调能力,缓解肌肉僵硬和震颤等症状。支持性治疗包括营养支持、呼吸支持和心理支持等,可以提高患者的生活质量。
原文地址: https://www.cveoy.top/t/topic/bDv2 著作权归作者所有。请勿转载和采集!